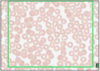
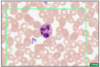
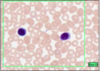
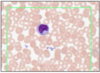

CV Flashcards
(24 cards)

CARDIAC MUSCLE (MYOCARDIUM)
- branching chains of cardiac myocytes
- striations (myofibrils and repeat sarcolemmas)
- dark intercalated discks (myocyte junctions)
differ from skeletal -
- structural - branched, mononuclear (central), no stem cells
- physiological - contract/relax without rest, secrete hormones (ANP- when stretched excessibely, increases water/Na+/K+ excretion, inhibits RAAS)

INTERCALATED DISC
- w/ desmosomes + adherent junctions (stick)
- w/ gap junctions (electrical coupling)
disc = black
myofibrial = blue/black
function:
desmosome - anchor one cardiac muscle to next by immediate cytoskeleton filaments
gap junctions - allow ion transfer between cardiac smooth muscle
electrochemical coupling - not cardiac conduction

PURKINJE FIBRES (WITH PAS PROCEDURE - MAGENTA)
- large modified muscles
- large vacuoles
- few myofibrils therefore pale H&E
- stores of GLYCOGEN (PAS)
CARDIAC CONDUCTION

ARTERY - LEFT, VEIN - RIGHT
- 3 layers
- intima (innermost) - endothelial cells on loose connective tissue w/ occasional myo-intimal cells (contractile potential)
- media (middle) - thicker in arteries than in veins - smooth muscle, elastic, collagen
- adventitia (outermost) - dense collagen and elastic

MUSCULAR ARTERY
- well defined medial layer (smooth muscle in concentric rings)
- medial layer interspersed with elastic
- media-intima divide = wavy internal elastic lamina (condensed perforated elastic)
- adventitia-media divie = external elastic lamina only in large muscular

ARTERY WITH PLAQUE AND THROMBUS (WITH IRON HAEMATOXYLIN)
- elastic/nucleus = black

ELASTIC ARTERY (WITH MALLORY’S STAIN)
- elastic - red / collagen & muscle - blue
- = aorta and GT vessels close to heart
- medial layer thick w/concentric sheets of elastic interspersed w/smooth muscle
- as vessels large - contain own blood supply vasa vasorum
at top = intima then internal elastic lamina, then vascular endothelial cells on BM

ARTERIOLES
- 3 layers or fewer of muscle @ media
- no internal elastic lamina - therefore amy completely close when muscle contracts
- poor adventitia - mainly collagen and elastin
function: highly responsive to vasoactive stimuli - regulation of TPR

CAPILLARIES
- sometimes have contractile pericytes along bed
- continuous or fenestrated (gut, kidney glomerulus, endocrine glands)
- diameter is size of RBC
this slide - mature adipose

ENDOTHELIAL CELLS (EM)
- specialised - release vasoactive substances
- capillary @ centre
function:
- active transport of molecules across cytoplasm
- influence muscle tone
- coagulation
- produce cell adhesion molecules - influsence lymphocyte/neutrophil migration

VENULES
- thin walled
- pericytes alongside them
- pericytes become continuous as vessel gets bigger
- in veins no pericytes, replaced by smooth muscle
- irregular outline

VEINS (TOP LEFT x2)
- same layers as arteries, but thinner and poor boundaries
- irregular outline, large lumne (therefore same blood at lower pressure)
- wider lumen than arterioles (but slower flow) therefore same volume/sec

LARGE VEINS
- thick wall
- distince intima/media and internal elastic lamina
- medial layer w/ longitudinal smooth muscle
- adventitia - thick w/ longitudinally arranged muscle fibres

LYMPH VESSELS
- w/ pink staining blood plasma and valves
- small = like capillaries
- large = like veins
- walls = connective tissue with some muscle
- less pressure than venules
- sometimes lymphocytes
- transports antigens and activated lymphocytes from tissue to lymph nodes (and resident macrophage)
- drains excess fluid fro tissue (hydrostatic/oncotic pressure imbalance)
- no blood
RBC (LEISHMAN’S STAIN - TYPE OF ROMANOVSKY SMEARS)
- 44% of blood
- anucleate - leads to biconcavity
- 120 day lifespan

RETICULOCYTES
- mature RBC loses cytoplasm and nucleus
- reticulocytes = immature RBC w/ some visible ribosomes, ie. some dark staining granules
- increased number with increased RBC produciton
EOSINOPHILS (ROMANOVSKY/LEISHMAN’S)
- 2-3 lobe nucleus
- bright pink granules
- acidophils
- circulate for a few hours
- diurnal - highest in morning
- phagocytose antigen/antibody complexes, associated w/ parasitic infection
- neutralise histamine
GRANULOCYTES

NEUTROPHILS - POLYMORPHONUCLEAR LEUKOCYTES (LEISHMAN’S STAIN)
- multi-lobar nucleus
- most numerous
- phagocytic
- engulf and destroy bacteria
- leave blood stream to enter tissue @ infection site
fine granules = GRANULOCYTES
- primary - lysosomes, acid hydrolases, antibac and digest
- secondary - neutrophil specific, regulation of inflammation response
- tertiary - facilitate insertion of proteis to cell membrane
lobes = 2-4, number increases with age

BASOPHILS - BASOPHILIC LEUKOCYTES
- not multi-lobar
- dark blue granules which appear to fill cell
- least common
- similar role to MAST cells
- secrete HISTAMINE and other vasoactive substances - increased blood flow locally
LYMPHOCYTES
- small cells with dark stained nucleus and little cytoplasm
- B and T are indistinguishable
- immature are bigger than RBC, smaller than granulocytes
- mature roughly equal size to granulocyte
MONOCYTES
- kidney-shaped nucleus
- no granules
- pale blue cytoplasm
- immature cells which differentiate to one of various forms when leave blood and enter connective tissue
- many to macrophages (fixed marcophage @ liver = Kupffer, and @ spleen)
in blood and alveolar air spaces
macrophage phagocytotic, actute inflammation, arrive after neutrophils

PLATELETS
- smaller than red cell
- anucleate
- fragements
- from multinuclear megakaryocytes
- blue
- 4 types of granules:
- alpha - clotting
- dense
- lysosomes
- peroxisomes - elimination of oxygen radicals

MUSCULAR ARTERY 2
- circumferential sm @ media
- when this contracts reduces diameter of vessel

ELASTIC TISSUE (ELASTIC VAN GIESON’S WITH IRON HAEMATOXYLIN COUNTER STAIN
- elastic tissue in tube like sheets - elastic lamina
- elastic = black
- sm = mushroom
- collagen = pink


